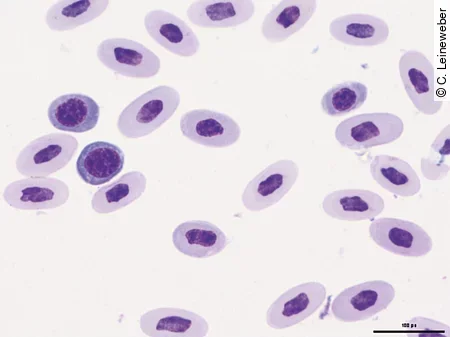
Im Blutausstrich eines Jemenchamäleons erkennt man eine regenerative Anämie.
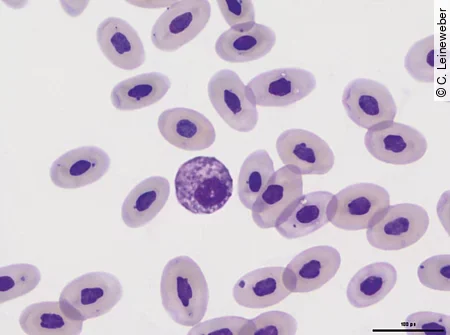
Im Blutausstrich einer Bartagame kann man einen eosinophilen Granulozyten erkennen.
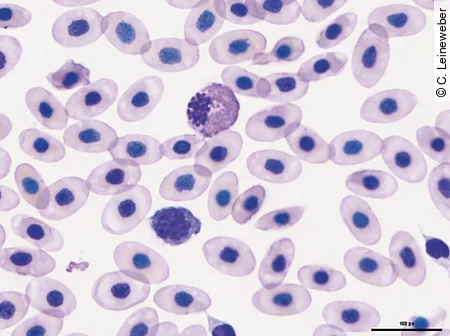
Im Blutausstrich eines Grünen Leguans kann man einen Lymphozyt und einen heterophilen Granulozyten erkennen.
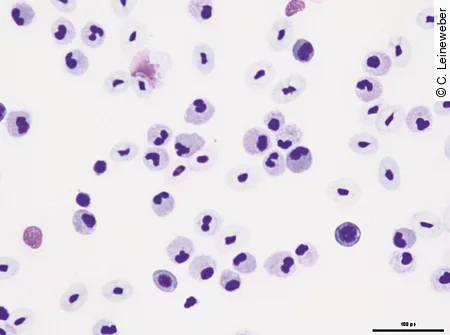
Im Blutausstrich einer Bartagame ist eine deutliche Leukozytose erkennbar.
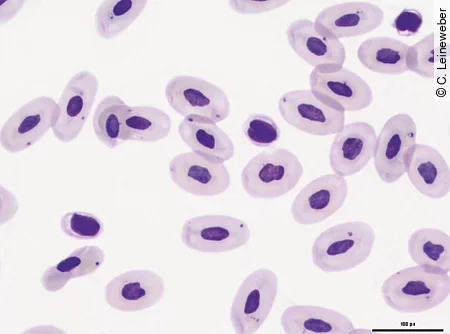
Die Thrombozyten im Blutausstrich einer Bartagame sind klar von den Erythrozyten zu unterscheiden.

Inhalt

Echsen sind neben Schildkröten die am häufigsten gehaltenen Reptilien in deutschen Haushalten. Es gibt eine ganze Reihe verschiedenster Arten, vom Leopardgecko über das Pantherchamäleon bis hin zum Grünen Leguan, die regelmäßig als Haustiere gehalten werden. Am häufigsten wird die aus Australien stammende Streifenköpfige Bartagame gehalten. Alle Arten stellen sowohl an den Haltenden als auch die behandelnden Tierärzt*innen aufgrund ihrer Physiologie und unterschiedlichen Lebensweise besondere Ansprüche.
Wo entnehme ich das Blut?
Prinzipiell stellt die ventrale Schwanzvene (V. coccygealis ventralis), die sich ventral der Wirbelsäule im Schwanz befindet, die beste und sicherste Entnahmestelle bei Echsen dar. Je nach Art und Größe der Echsen gibt es jedoch Unterschiede.
- Kleine Echsen: Die Blutabnahme erfolgt bei Agamen, Chamäleons, größeren Geckos und kleineren Leguanen von ventral, wobei im 45 – 90° Winkel medial kraniodorsal in Richtung Wirbelsäule eingestochen wird. Die Echse wird dabei von einer 2. Person gehalten und leicht auf den Rücken gedreht ([Abb. 1 a] und [b], [Abb. 2]).


- Große Echsen: Bei großen Leguanen und Waranen, die sich deutlich schwerer händeln lassen und zum Teil auch sehr wehrhaft sind, ist es einfacher, die Tiere in Bauchlage auf dem Tisch zu fixieren und dann lateral circa mittig in den Schwanz im 45 – 90° Winkel einzustechen, um ebenfalls die ventrale Schwanzvene zu punktieren.
Bei der Punktion der Schwanzvene ist es wichtig, mehrere Dinge zu beachten. Zum einen dürfen bei männlichen Tieren keinesfalls die Hemipenistaschen und die aufhängende Muskulatur durch Punktion beschädigt werden, da es sonst zu einem irreversiblen Hemipenisvorfall kommen kann.
Zum anderen müssen tierartspezifische Besonderheiten beachtet werden:
- So kann es bei Chamäleons zu einer Schwarzfärbung des Schwanzes kaudal der Punktionsstelle kommen, die zum Teil bis zu mehreren Monaten anhalten kann. Der Tierhaltende sollte zwingend vorher darüber aufgeklärt werden.
- Durch ungeübte mehrfache Punktion mit zu großen Kanülen kann es durch Innervationsprobleme zu einer Schwanznekrose, häufiger auch bei Chamäleons, kommen.
- Bei Arten wie vor allem Geckos, die zur Autotomie fähig sind, kann es zum Abwerfen des Schwanzes kommen. Daher sollten hier möglichst kleine Kanülen verwendet werden. Zum Teil hat es sich sogar bewährt, Insulinspritzen mit integrierter Kanüle zu verwenden. Durch den geringen Durchmesser besteht aber ein höheres Hämolyserisiko. Um die Tiere leichter händeln zu können und so eine sichere Blutabnahme zu ermöglichen, besteht auch die Möglichkeit einer leichten Narkose bzw. Sedierung.
Eine andere Punktionsstelle ist die Abdominalvene, die medial unter der Bauchhaut verläuft und sich kurz vor der Kloake aufgabelt. Diese ist bei einigen Geckos wie dem Leopardgecko mithilfe einer Durchleuchtung durch die Haut sogar sichtbar. Bei größeren Arten ist es auch möglich, die V. jugularis oder den axillaren Plexus zu punktieren.
Wie viel Blut darf ich entnehmen?
Wie bei anderen Reptilien entsprechen etwa 5 – 8% des Körpergewichts dem Blutvolumen der Tiere, wovon auch hier bis zu 10% entnommen werden können, ohne das Tier zu schädigen.
Merke
Als Faustregel gilt, dass maximal 0,7 ml/100 g Körpergewicht pro Blutentnahme entnommen werden dürfen.
Dies ist jedoch auch vom klinischen Zustand des Patienten abhängig.
Bei kleinen Arten < 100 g [Abb. 3] empfiehlt es sich oft Inhouse-Geräte zu nutzen, da diese oft nur sehr wenig Material benötigen. Auch die Anfertigung eines Blutausstrichs aus 1 Tropfen Blut kann sehr hilfreich sein.

Was schicke ich ins Labor?
Dies hängt stark davon ab, welche Untersuchungen gewünscht sind und wie groß die gewonnene Probenmenge ist.
Reptilien haben zum Teil eine stark verzögerte Blutgerinnung. Es sollte daher statt Serum besser Plasma verwendet werden, um ein Nachgerinnen der Probe zu verhindern.
Hier haben sich aus mehreren Gründen Heparin bzw. Lithium-Heparin-Röhrchen bewehrt [Abb. 4]. Bei kleinen Reptilien und langsamen Blutfluss empfiehlt es sich bereits die Kanüle und die Spritze mit Heparin zu benetzen, um eine Gerinnselbildung zu verhindern.

Das Lithium-Heparin-Vollblut kann zur Erstellung eines Blutbilds verwendet werden und das durch Abzentrifugieren gewonnene Plasma zur Bestimmung der klinisch-chemischen Laborparameter. Um einen möglichst guten Zellerhalt für die Erstellung eines Differenzialblutbilds zu ermöglichen, ist es ratsam, direkt nach der Abnahme einen Blutausstrich anzufertigen und diesen luftgetrocknet und ungefärbt einzuschicken. Bei Echsen kann auch EDTA-Vollblut für die Erstellung eines Blutbilds verwendet werden. Es ist jedoch nicht möglich aus dem EDTA-Plasma Elektrolyte wie Kalzium, Kalium oder Magnesium zu bestimmen. Auch die Bestimmung der alkalischen Phosphatase wird durch dieses Antikoagulans gestört.
Welche diagnostischen Hinweise gibt die hämatologische Untersuchung?
Hämatokrit
Die Bestimmung des Hämatokrits liefert im erniedrigten Bereich Hinweise auf eine Anämie. Eine Erhöhung ist ein Zeichen für eine Dehydrierung. Beachtet werden muss jedoch, dass das Blut bei der Abnahme nicht mit Lymphflüssigkeit kontaminiert sein darf.
Erythrozyten
Im Blutausstrich kann dann zusätzlich die Morphologie der Erythrozyten und deren Vorläuferzellen beurteilt werden, um einen Hinweis darauf zu bekommen, ob das Tier eine regenerative [Abb. 5] oder aregenerative Anämie hat.
Die Anämieursachen sind beim Reptil ähnlich wie beim Säuger. So können hämorrhagische Anämien durch Trauma oder Blutparasiten ausgelöst werden, letztere können evtl. mittels Blutausstrich diagnostiziert werden. Die Ursache für hämolytische Anämien sind häufig Septikämie, Parasiten oder Toxämien. Blutparasiten finden sich bei Echsen jedoch sehr selten und in der Regel eher bei Wildfängen. Nicht regenerative Anämien kommen häufig im Zusammenhang mit chronisch-entzündlichen Prozessen, chronischen Erkrankungen von Niere und Leber, Neoplasien oder durch Medikamente vor.
Einflussfaktoren
Wichtig ist, dass die Blutparameter bei Reptilien von einer Reihe von Faktoren wie Geschlecht, Alter, Jahreszeit, Ernährung und Haltungsbedingungen beeinflusst werden können. Spezies, die eine Winterruhe halten wie Bartagamen oder Halsbandleguane, haben direkt danach häufig einen höheren Hämatokrit. Die prozentuale Verteilung der Leukozytenpopulationen wird auch durch die Jahreszeit beeinflusst. So ist die Anzahl der Heterophilen und Lymphozyten im Sommer am höchsten, wohingegen die Anzahl der Eosinophilen bei Arten mit Winterruhe im Winter am höchsten ist.
Leukozyten
Die Schätzung der Leukozytengesamtzahl sowie die morphologische Beurteilung erfolgt auch durch mikroskopische Beurteilung des Blutausstrichs, da eine maschinelle Messung mittels hämatologischer Analysegeräte wie bei Säugern nicht möglich ist. Auch die mikroskopische Differenzierung erfordert eine gewisse Erfahrung, da die Morphologie der Zellen sich zum Teil sehr stark zwischen den Arten unterscheidet und auch die Nomenklatur der Zellen in der Literatur zum Teil sehr unterschiedlich ist. Die hier beschriebenen morphologischen und besonders farblichen Besonderheiten der Zellen beziehen sich auf die häufig verwendete Wright-Giemsa- oder auch Diff-Quick-Färbung. Häufig wird unterschieden zwischen heterophilen, eosinophilen und basophilen Granulozyten sowie Lymphozyten und Monozyten, die zum Teil noch in Azurophile unterteilt werden können.
Heterophile
Sie stellen sich bei Echsen als große runde Zellen mit oft segmentiertem Kern und farblose Zytoplasma dar. Anders als bei Schlangen und Schildkröten findet man bei Echsen [Abb. 6] häufig nicht so viel spindelförmige eosinophile (orange) Granula. Wenn die Zelle toxisch reagiert, findet man ein basophiles Zytoplasma und zum Teil basophile runde Granula, die auch als zytotoxische Granula bezeichnet werden, im Zytoplasma. Heterophile stellen mit über 40% bei den meisten Reptilien die größte Leukozytenpopulation dar. Ein Anstieg der Heterophilen tritt häufig im Zusammenhang mit bakteriellen oder parasitären Infektionen auf, aber auch Stress und Neoplasien können eine Ursache sein.

Eosinophile
Die Eosinophilen bei Echsen sind kleiner als bei Schlangen und Schildkröten und sind gekennzeichnet durch basophiles Zytoplasma, oft runde eosinophile Granula und einen runden oder oft auch segmentierten Kern. Bei Grünen Leguanen und einigen anderen Echsenarten sind die Granula nicht eosinophil, sondern färben sich bläulich an [Abb. 7]. Einen Anstieg der Eosinophilen findet man bei parasitären Infektionen, aber auch als Zeichen einer Stimulation des Immunsystems.
Basophile
Es sind kleine runde Zellen mit dunkler basophiler, oft lilafarbener, runder Granula, die häufig den runden zentral liegenden Zellkern verdecken. Im Gegensatz zu Schildkröten findet man bei Echsen aber nur wenige eosinophile und basophile Granulozyten.
Lymphozyten
Die Zellen stellen sich als runde Zellen mit rundem, zentralen Kern dar, der von einem basophilen oft homogen gefärbten Plasmasaum umgeben wird [Abb. 8]. Neben den sogenannten „kleinen Lymphozyten“ gibt es jedoch auch Lymphozyten mit einem etwas blasser gefärbtem basophilen Kern und mehr basophilem Zytoplasma. Diese sind etwas größer und werden daher als „große Lymphozyten“ bezeichnet.
Bei Reaktion der Lymphozyten wird der Kern zum Teil oval und verschiebt sich an den Rand. Deutlicher sind jedoch das nun dunkelblau verfärbte Zytoplasma und die zum Teil im Zytoplasma vorkommenden Vakuolen. Diese Zellen werden als reaktive Lymphozyten und später auch als Plasmazellen bezeichnet.
Lymphozyten stellen je nach Reptilienart neben den Heterophilen die zweithäufigste oder sogar häufigste Leukozytenpopulation im Blut dar. Eine Lymphopenie kann ein Zeichen von Immunsuppression, chronischem Stress oder Unterernährung sein. Eine Lymphozytose [Abb. 9] kommt hingegen bei Wundheilungen, viralen Infektionen und einigen parasitären Infektionen vor.
Leukämie
Leukämien sind bei Reptilien bisher wenig beschrieben worden, können aber ab und zu diagnostiziert werden. Bei der lymphoiden Leukämie kommt es zu einer starken Leukozytose mit vermehrt unreifen und abnormalen Lymphozyten sowie Blasten.
Monozyten
Sie stellen die größten Zellen im Blutausstrich dar. Sie sind rund bis amöboid und haben einen runden bis länglich segmentierten Kern. Der Kern und das Zytoplasma sind etwas heller gefärbt als bei Lymphozyten, sodass das Zytoplasma sich hellblau bis gräulich darstellt und häufig auch Vakuolen oder feine eosinophile Granula enthält. Monozytosen kommen am häufigsten im Zusammenhang mit granulozytären Infektionen vor. Azurophile sind etwas kleiner als Monozyten, haben oft einen runden Kern und dunkler gefärbtes blaues bis lavendelfarbendes Zytoplasma [Abb. 10]. Aufgrund ihres ultrastrukturellen und biochemischen Verhaltens werden sie zu den Monozyten gezählt.

Thrombozyten
Thrombozyten sind kleiner als die Erythrozyten, meist ellipsoid mit ovalem Kern im Zentrum und farblosem bis schwach basophilem Zytoplasma [Abb. 11]. Oft liegen die Thrombozyten im Ausstrich in Form von Aggregaten vor, was auch durch Lithium-Heparin begünstigt wird.
Welche klinisch-chemischen Parameter sind bei Echsen besonders wichtig?
Der Stoffwechsel von Reptilien und so auch die Blutparameter werden durch eine Reihe von Faktoren beeinflusst:
- Geschlecht
- Alter
- Haltung
- Ernährung
- Jahreszeit
- physiologische Prozesse wie die Fortpflanzung
Es ist nicht möglich, alle diese Faktoren bei der Etablierung von Referenzwerten zu beachten. Daher ist es umso wichtiger, die Befunde der klinisch-chemischen Blutuntersuchung immer im Zusammenhang mit der Anamnese und den Befunden aus der klinischen Untersuchung des Patienten zu interpretieren. Die bestehenden Referenzwerte können so oft nur hinweisend genutzt werden und sind auch nur für wenige Arten überhaupt verfügbar. Eine Möglichkeit vergleichbare Laborwerte zu erhalten, ist die Erstellung tierindividueller Referenzbereiche. Dazu entnimmt man beim gesunden Tier Blut und nutzt die Ergebnisse im Krankheitsfall dann als Vergleichswerte.
Harnsäure
Da Echsen in der Regel terrestrisch leben und viele wie die häufig gehaltene Bartagame oder der Leopardgecko aus Wüstenregionen stammen, ist ihr Körper sehr darauf ausgelegt Wasser zu sparen. Die nierenpflichtigen Stoffe werden daher in Form kristalliner Harnsäure ausgeschieden, sodass der Harnsäuregehalt im Blut als wichtigster Nierenparameter angesehen werden kann.
Merke
Wichtig für die Beurteilung der Harnsäure ist, ob das Tier vor der Blutentnahme gefressen hat.
Gerade bei carnivoren, aber auch insektivoren Arten kann die Harnsäure je nach Verdauungsphysiologie Stunden bis wenige Tage nach der Futteraufnahme physiologisch erhöht sein. Auch der Hydrationsstatus des Patienten spielt eine Rolle.
Pathologische Zustände, die zu einer Hyperurikämie führen können, sind häufig Nierenerkrankungen im Zusammenhang mit Bakteriämie, Septikämie, Nephrokalzinose und nephrotoxischen Stoffen.
Phosphat
Bei starken Nierenschäden kann es auch zu einer Hyperphosphatämie kommen, die aber auch durch eine gesteigerte Aufnahme mit der Nahrung, eine Hypervitaminose D3 oder eine osteolytische Knochenerkrankung ausgelöst sein kann. Eine Hypophosphatämie wird v. a. durch zu geringe Aufnahme mit der Nahrung verursacht.
Kalzium
Der Kalziumstoffwechsel bei Reptilien ist ähnlich wie bei Säugern über Parathormon, Vitamin D3 und Calcitonin reguliert und sollte unter physiologischen Bedingungen und adäquater Ernährung wenig schwanken.
Eine Ausnahme sind jedoch weibliche Tiere während der Follikelbildung, da es hier zu einem 2 – 4-fachen Anstieg des Gesamtkalziums während der Follikelbildung noch vor der Ovulation kommen kann. Auch die Zufuhr von UV-B-Licht, das die Vitamin-D3-Synthese anregt, ist ein wichtiger Einflussfaktor, der beachtet werden muss.
Pathologische Zustände, die zu einer Hypokalzämie führen sind:
- Hyperphosphatämie
- Alkalose
- Hypoalbuminämie
- Hypoparathyreoidismus
Jungtiere, die zu wenig Kalzium und zu viel Phosphat mit der Nahrung aufnehmen und zusätzlich einen Vitamin-D3-Mangel haben, können einen sekundären Hyperparathyreoidismus und eine sogenannte metabolische Knochenkrankheit (metabolic bone disease) entwickeln.
Eine Hyperkalzämie wird in der Regel iatrogen durch exzessive Kalzium- und Vitamin-D3-Zufuhr verursacht und nur sehr selten durch einen primären Hyperparathyreoidismus, Pseudohyperparathyreoidismus oder eine osteolytische Knochenerkrankung.
Die Messung von ionisiertem Kalzium ist möglich [3], in der Praxis jedoch schwierig, da das Plasma unter Luftabschluss gewonnen und analysiert werden muss.
Leberenzyme
Die Beurteilung der Leberfunktion ist bei Reptilien nicht so einfach, da viele der Leberenzyme auch in anderen Organen vorkommen. Die Aspartat-Aminotransferase (AST) kommt auch in der Muskulatur vor und muss daher immer im Zusammenhang mit der Kreatinkinase (CK) beurteilt werden, welche als Muskelparameter dient. Die Alanin-Aminotransferase (ALT) kommt in Leber- und Nierenzellen vor. Eine erhöhte alkalische Phosphatase (AP) kann nicht nur auf einen Leberzellschaden hinweisen, sondern auch auf eine erhöhte Osteoblastenaktivität, die bei wachsenden Tieren physiologisch ist.
Die Glutamatdehydrogenase (GLDH) kommt in den Mitochondrien der Hepatozyten vor und wird durch Leberzellschäden freigesetzt. Dieses Enzym ist nach bisherigen Erkenntnissen sehr spezifisch. Den meisten Reptilien fehlt das Enzym, welches das grüne Biliverdin zu Bilirubin umwandelt. Daher ist eine grüne Färbung des Plasmas eher hinweisend für eine Lebererkrankung. Daneben nehmen herbivore Arten wie Grüne Leguane und Dornschwanzagamen auch viele Pflanzenfarbstoffe mit der Nahrung auf, die das Plasma gelb färben.
Für die Gallensäure als Funktionsparameter bei Reptilien gibt es bisher wenige Referenzwerte. Als weiterer Funktionsparameter für die Leber können das Gesamteiweiß und vor allem das Albumin betrachtet werden.
Eine Hypoproteinämie kann folgende Ursachen haben:
- chronische Lebererkrankung
- Unterernährung
- Verdauungsstörung
- Proteinverlust-Enteropathie
- Blutverlust
- chronische Nierenerkrankung
Hyperproteinämien hingegen sind Zeichen einer Dehydration oder einer Hyperglobulinämie infolge eines entzündlichen Prozesses.
Die Messung von Albumin sollte durch Auftrennung der Plasmaproteine mittels Elektrophorese erfolgen, welche gleichzeitig auch noch die Beurteilung der Globulinfraktionen ermöglicht und daher in Zukunft das Diagnostikum der Wahl sein wird, um Proteinverschiebungen sicher diagnostizieren zu können.
Fazit
Die Blutuntersuchung ist neben der klinischen Untersuchung des Patienten und der Bildgebung eines der wichtigsten Diagnostika zur Evaluation des Gesundheitszustands. Gerade bei Reptilien wie den Echsen, die oft wenig klinische Symptomatik zeigen, kann sie wichtige Informationen liefern, zum Beispiel im Hinblick auf Leber- und Nierenerkrankungen, aber auch auf Entzündungen. Sie kann helfen eine Diagnose zu stellen bzw. Differenzialdiagnosen auszuschließen.
Der Originalbeitrag zum Nachlesen:
Leineweber C, Marschang R E. Nehmen wir doch mal Blut! – Auf was man bei Echsen bei der Blutuntersuchung achten sollte. kleintier konkret 2019; 22(S01): 22 - 28. doi:10.1055/a-0842-3630
(JD)



